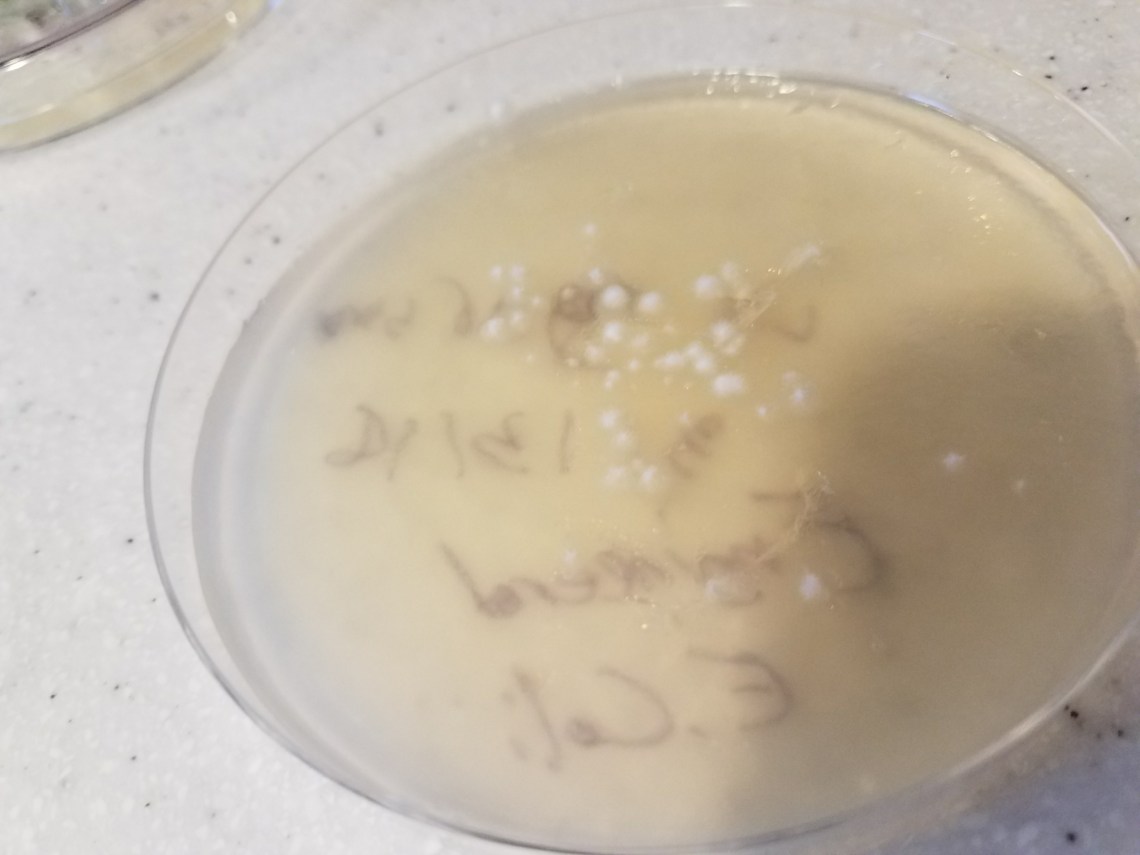
20180325_181739_resized

Tenille recently sent me an article about rising insulin prices:
http://harvardpolitics.com/united-states/how-insulin-became-unaffordable/
Basically, the summary is that there are a few companies that hold the patents on modern day insulin and have increased prices from $20 to $200 per vial effectively making it unaffordable for many with diabetes. I started to do a little bit of research on the subject wondering if there were not alternatives.
It ends up that Insulin in Canada is considerably cheaper. There were also efforts to create Open Source Insulin, where community labs are trying to come up with designs and methods to allow anyone to create insulin. Therapy for diabetics started in the 1920s when scientists took the pancreas of pigs and mashed it up into a slurry. Since then, we’ve been able to engineer bacteria and yeast to express human insulin, purify it, and preserve it.
Unfortunately, these techniques and even DNA sequences are patented and controlled by a few companies that continue to raise prices. Although many of the patents have expired, they keep modifying it just enough to keep their drugs under patent protection.
With this as our motivation, Caleb, Andrew, and I have been exploring bioengineering. We heard of a technique called CRISPR where you can inject in segments of DNA into the DNA strands of living organisms. We found a company called ODIN that sells experiment kits. We did our first experiment where we took E Coli bacteria and inserted into its DNA a mutation so that it can survive in an environment where it normally could not.
We prepared Agar plates together. Then, grew E. Coli in them.
Yes, we are growing E. Coli at our kitchen table where we eat about 90% of our meals. Likely you have eaten on this table with us. (It was non-pathogenic E. Coli and we usually washed our hands…)
Here is a picture of some E. Coli art.

We used various chemicals to prepare the E Coli bacteria. We used CAS9 to snip the bacteria’s DNA in specific places, then inserted in our own DNA mutation, so that they could live in a normally hostile environment. We had fun learning how to pipette. (I think that’s a verb… )

Finally, we put the transformed E. Coli in the hostile environment and watched it grow, while the unchanged E. Coli could not survive…
Our next experiment is to take yeast and make it produce proteins that fluoresce. We have prepared some more agar plates.
As part of the learning, Caleb and I visited the Open Insulin group. They are based out of a small community lab called Counter Culture Labs in Oakland, CA. It was a group of about 8 people. They have been able to produce Pro-Insulin (which is a form of insulin as it is produced in the pancreas) from E Coli and Yeast. However, to make it into real insulin, it gets complicated. In Pro-Insulin, there are 3 chains of amino acids – A, B, and C. A and B must separate, then fold up correctly, then rebind to each other. The C chain gets thrown away. Once A and B transform and bond, then you have real insulin.

They are looking at different ways to make this happen that does not infringe on existing patents. They want to make this information public so that co-ops of patients can get together and produce their own insulin cheaply. At least that’s the vision. But, the goal is pretty ambitious. There are all kinds of questions around safety, efficacy, and legality.
We got there a little bit late (because of the Bay area traffic), but luckily they started late and we got there as they started their meeting. They had video conferenced in with Bio-Curious, another community bio lab in California. They discussed their progress, next steps, and the issues they were running into. One of the bio-engineers wanted to synthesize a new DNA strand to try and address the folding and bonding issue. Apparently, it normally costs $500-$1000 to get this done (depending on the length of the strand.) They were trying to get it synthesized for free from a non-profit that helps projects like these, but it seemed like that was not going to happen. The group has some funds, but it is quite tight. They thought that this is something worth spending the cash on, so likely they will move ahead in synthesizing the new DNA strand.
After the meeting, we got a tour of the lab. They showed us the -80 C freezer, flow hood, centrifuges, PCRs, electrophoresis plates, how they purify proteins for analysis, and a spectroscopy machine.
It was neat to see all the interesting equipment required in this endeavor. It is definitely not a do it yourself at home type of project. I did some looking and there are some community bio labs in the Puget sound area – https://sound.bio/about/ http://www.hivebio.org/
These labs are all over: https://diybio.org/local/
Our local labs are in Seattle which would be a long way to drive to run experiments that may require daily attention. My guess is we could finagle our way into the Highline Community College biology lab if we had an interesting project idea…
The visit was definitely interesting and inspiring to see what volunteers can do. If nothing else to see what volunteers are trying to do. Hopefully, we’ll instill these values in our boys and try to live them in our family.